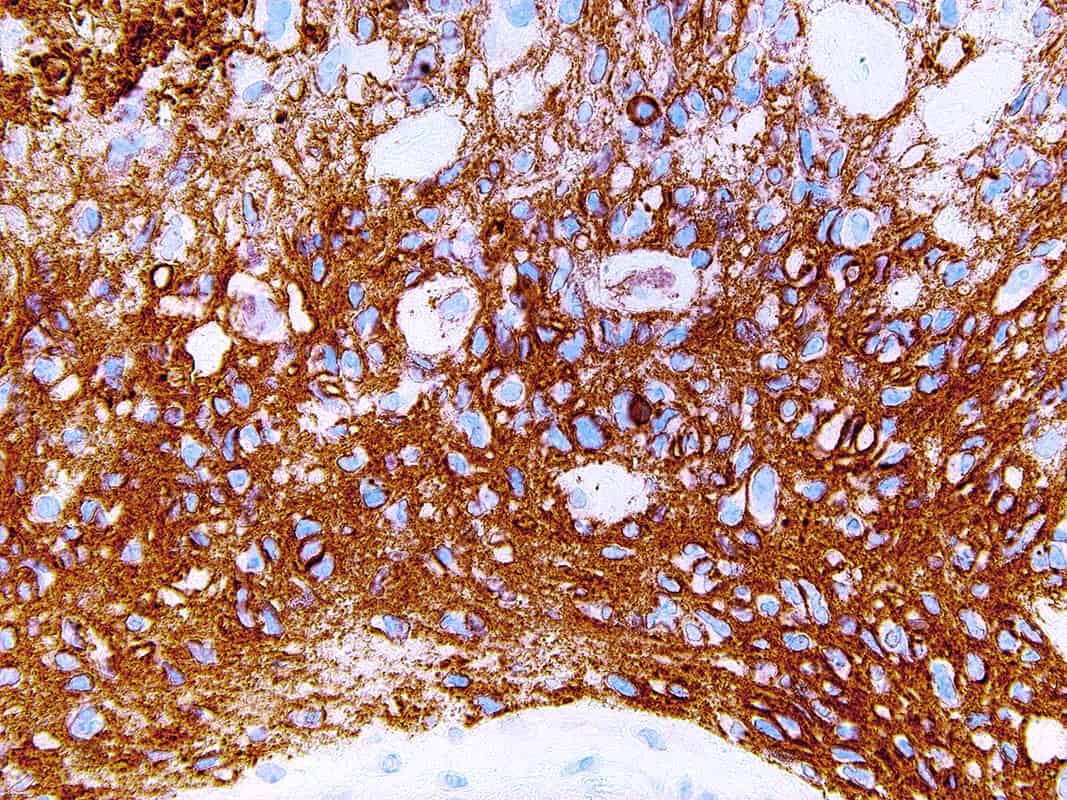

CD56
Cluster of differentiation 56 (CD56), also known as Neural-Cell Adhesion Molecule (NCAM), is a glycoprotein involved in synaptic plasticity, cell-cell adhesion, neurite outgrowth, learning, and memory. NCAM is expressed in normal neurons, glia, natural killer cells, activated T-cells, brain and cerebellum, neuroendocrine tissues, and skeletal muscle. Anti-CD56 recognizes a number of tumors including myeloma, myeloid leukemia, natural killer/T-cell lymphomas, neuroendocrine tumors, pancreatic acinar-cell carcinoma, pheochromocytoma, and Wilm’s tumor. CD56 is detectable in neoplasms that are neuroectodermally-derived, such as retinoblastoma, medulloblastomas, astrocytomas, small cell carcinomas, and neuroblastomas. It has also been linked to rhabdomyosarcoma, a tumor that is mesodermally-derived.
Specifications
| Clone | IHC056 |
| Source | Mouse Monoclonal |
| Positive Control | Neuroblastoma |
| Dilution Range | 1:50-1:200 |
Quantity
1.00
Select Volume
3 slides/package

Reviews
There are no reviews yet.